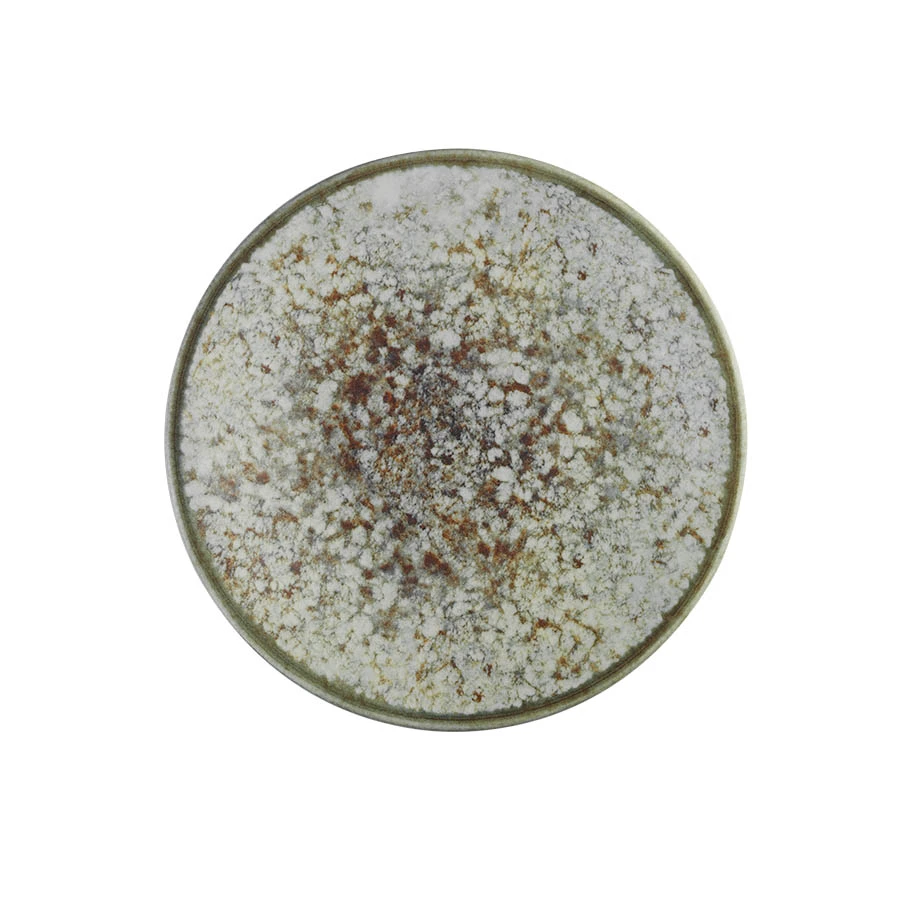

Школьная сумка, женский учащийся средней школы, рюкзак для старшеклассников, большой вместительный компьютерный рюкзак чёрный
График изменения цены & курс обмена валют
Пользователи также просматривали

1,709.46 руб.
For Mercedes Benz A1663300143 A1663300243 suspension steering lower control arm W292 GL350 GLS400 GLS320 GL500 GLS550 auto parts
aliexpress.com
2,110.19 руб.
New high-capacity 14.4V 4s2p 1C robot vacuum cleaner battery P1904 MM 38000mAh vacuum cleaner replacement parts
aliexpress.com
9,201.26 руб.
Spinning Bike Home Stationary Exercise Accessory Upright Bikes Fitness Equipment Indoor Cycling Iron Gym
aliexpress.com
1,643.90 руб.
Woolen Coat Men's Mid-length Windbreaker Korean Fashion Turn Down Collar Men's Woolen Coats 2022 Spring Autumn Clothes
aliexpress.com
926.03 руб.
Small Double-Sided Magnetic Whiteboard Dry Erase Portable Calendar Office Note Message Stand Easel Writing Tablet Black
aliexpress.com
1,189.90 руб.
Mens Plain Colo Baseball Tee Men's Autumn And Winter Casual Striped Contrast Color Lapel Jumpsuit Mens Big Shirts for Men
aliexpress.com
10,079.75 руб.
Настенное украшение в виде головы оленя, оригинальная Европейская статуя животного, подвесной фон для гостиной, скульптура, роспись, украше...
aliexpress.ru
157.34 руб.
LED Horloge Fitness Kleur Screen Smart Sport Armband Activiteit Running Tracker Hartslag Voor Mannen Vrouwen Siliconen Horloge
aliexpress.com
96.70 руб.
FHNBLJ Fashion Colorful Flowers Daisy Phone Case for iPhone 11 12 13 Mini Pro Xs Max 8 7 6 6S Plus X XR Solid Candy Color Case
aliexpress.com
12,053.09 руб.
Lintratek Booster المملكة العربية السعودية DHL التسليم السريع GSM 2G 3G 4G إشارة الداعم 900 1800 2100 LTE الإنترنت مكبر صوت UMTS
aliexpress.ru
5,942.96 руб.
2/3/5PCS Women Yoga Set Workout Sportswear Crop Top High Waist Leggings Sports Suits Women Sportswear Yoga Set Workout Clothes
aliexpress.com
43.43 руб.
2 шт. Сменные поворотные чашки для скейтборда Лонгборда грузовика 3,25-черный-12*10 мм
aliexpress.ru
2,583.86 руб.
Полиэтиленовые пакеты для почтовых отправлений размером 10x13 дюймов, синие/розовые, пластиковые пакеты для доставки с принтом зебры, курьерс...
aliexpress.ru
150.79 руб.
Трафареты с животными для рисования, цветовая фотография, альбом для скрапбукинга «сделай сам», декоративное тиснение, поделки для открыто...
aliexpress.ru
4,444.93 руб.
Защитная решетка радиатора, Крышка масляного радиатора для Ducati 899 959 1199 1299, черная алюминиевая сталь для мотоцикла
aliexpress.ru
2,382.26 руб.
RBQ2508 RBQ2508S RBQ2007 RBQC2007 RBQ2007S RBQC2007S RBQC2508 RBQC2508S короткая гидравлическая буферная серия QBQ QBQC
aliexpress.ru
1,983.17 руб.
Золотая Полоса трехмерная пряжа крашенная жаккардовая ткань, магазин швейных тканей нет на складе
aliexpress.ru
3,007.54 руб.
Слайдеры рамы мотоцикла для HONDA CB650R CB650F CB 650R 650F 2019 2020 2021, защита от ударов, защитная обтекатель
aliexpress.ru
308.13 руб.
Осенняя обувь для маленьких девочек, дизайнерская нескользящая обувь с бантом для малышей, на мягкой подошве, повседневная прогулочная обувь 2021
aliexpress.ru
21,771.00 руб.
Мужские кожаные туфли Bluchers с прямым мыском и двойной пряжкой Hackett, темно коричневый
cdek.shopping
164.78 руб.
Crazy Horse Texture Hülle Für Samsung Galaxy Xcover 6 Pro 5G, Einstellbare Ständer PU Leder -telefonabdeckung Mit Brieftasche - Braun, Galaxy Xcover6 Pro 5G
tvc-mall.com
786.30 руб.
Im-chen Shocksicheres Hülle Für Iphone 14 Plus Slim Phone Case Anti-kratzer-pc-rücken-edelstahl-rahmen-telefonschutzschutz - Schwarz, iPhone 14 Plus
tvc-mall.com
569.49 руб.
Langsdom D4c 3,5mm In-Ear-verdrahtete Dynamische Dynamische Treiber-Lautstärkeregelung HIFI-Headset Mit Mikrofon Für IPhone Samsung LG - Schwarz, iPhone 12 mini
tvc-mall.com
2,637.13 руб.
SPDT G3/4 порт 1-100C управление расходом жидкости реле расхода 10Bar 5A 250V
aliexpress.ru
1,245.63 руб.
2020 модные джинсы-бойфренды для женщин, джинсы с высокой талией для мам, джинсы-шаровары черного цвета, женские джинсовые брюки, уличная одеж...
aliexpress.ru
733.45 руб.
100 шт./лот 100 X круглая Светодиодная лампа-вспышка, шарик, светильник, длительное время работы в режиме ожидания, бумажный фонарь, шар, светиль...
aliexpress.ru
1,638.16 руб.
Милое Хлопковое платье для маленьких девочек, хлопковые платья с коротким рукавом для девочек, летняя крутая повседневная одежда, детская о...
aliexpress.ru
145.05 руб.
Шнурок для ожерелья с бусинами, цепочка для ожерелья, разноцветный шнурок с бусинами для очков LL @ 17
aliexpress.ru